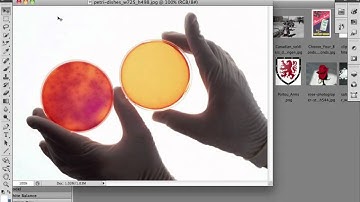
Photoshop CS5 - Open Files and Bridge

⬇ DOWNLOAD NOW
Kalau muncul iklan pop-up, tutup lalu klik tombol kembali
Download lagu How to Import Pictures File to an Existing PSD in Photoshop CS5 secara gratis hanya untuk keperluan promosi. Dukung artis favorit kamu dengan membeli musik original di iTunes atau platform resmi lainnya.
 How to Import Pictures File to an Existing PSD in Photoshop
How to Import Pictures File to an Existing PSD in Photoshop
 Importing multiple images into Adobe Photoshop CS5
Importing multiple images into Adobe Photoshop CS5
 How to Add Images into Existing PSD - Photoshop CC
How to Add Images into Existing PSD - Photoshop CC
 How to insert an image in photoshop 2025
How to insert an image in photoshop 2025
 Adobe Photoshop - How to Place an Image Into an Existing Document Import an Image
Adobe Photoshop - How to Place an Image Into an Existing Document Import an Image
Photoshop CS5 - Open Files and Bridge
Photoshop CS5 - Open Files and Bridge
 Adobe Photoshop CC Beginners Tutorial - How To Import Photos
Adobe Photoshop CC Beginners Tutorial - How To Import Photos
 Opening an image and placing an image in an existing document in Photoshop CC 2018
Opening an image and placing an image in an existing document in Photoshop CC 2018